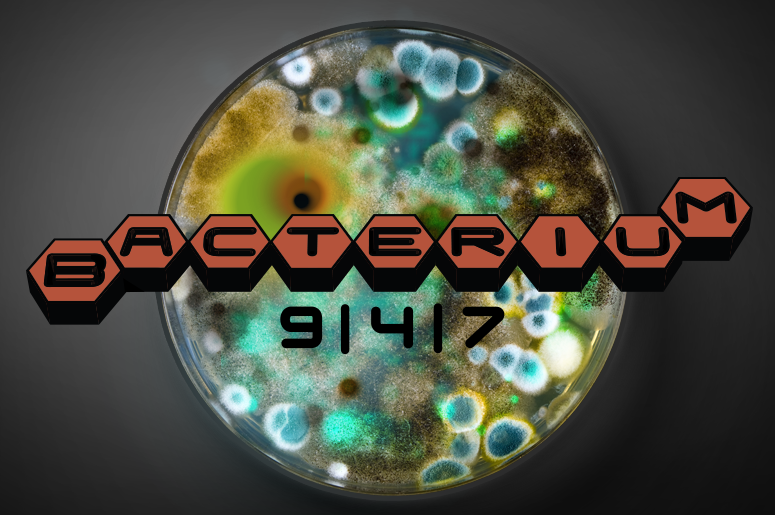

BacteriuM: 9 | 4 | 7
BacteriuM: 9 | 4 | 7 is the only show in Sacramento where you can hear an infectious blend of alternative, indie, electronic, hip-hop, and dance all rolled into your morning commute.
Hear a new mix created by Sacramento’s very own, Zephyr, every weekday morning starting at 8:00am. And NOW you can relive the most popular playlist around as we replay BacteriuM: 9 | 4 | 7 on Saturday's from 9PM - MIDNIGHT! As Sacramento News and Review’s Sammie winner for Best Deejay two years in a row, Zephyr is dedicated to creating mixes on ALT 94.7 that will wake you up in the morning.
BacteriuM: 9 | 4 | 7 will contaminate your morning commute.